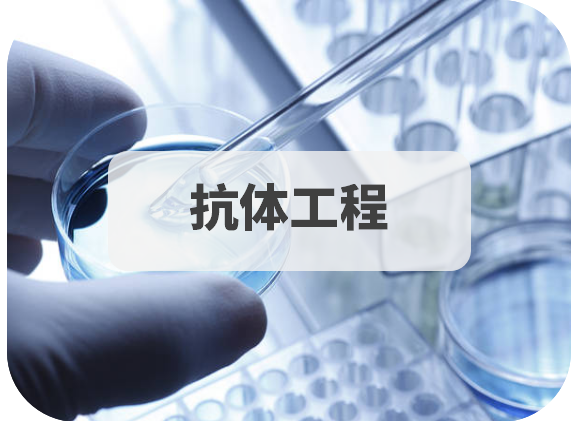
抗體工程.png

單克隆抗體分子在藥物研發(fā)�、診斷試劑開(kāi)發(fā)中扮演了關(guān)鍵的角色���?���?贵w分子的一級(jí)結(jié)構(gòu),特別是其CDR區(qū)域的氨基酸序列是發(fā)揮其生物學(xué)功能的核心��,對(duì)其完整序列準(zhǔn)確快速的分析具有重要的意義�。
輝駿生物基于高精度、高分辨率質(zhì)譜設(shè)備����,結(jié)合自主研發(fā)的測(cè)序技術(shù)平臺(tái),能夠?qū)崿F(xiàn)對(duì)抗體氨基酸序列的精準(zhǔn)解讀����。同時(shí),我們有自建的高通量表達(dá)驗(yàn)證平臺(tái)���,能夠?qū)σ褱y(cè)得的抗體序列進(jìn)行高通量表達(dá)驗(yàn)證,從而保證交付抗體的活性���。
抗體測(cè)序 * 應(yīng)用方向

獲得抗體序列�,快速地制備低成本、高質(zhì)量重組抗體����,解決抗體原料批次間差異等問(wèn)題

準(zhǔn)確的一級(jí)結(jié)構(gòu)信息是進(jìn)行藥物研發(fā)的前提,通過(guò)抗體測(cè)序分析���,為抗體藥的研發(fā)奠定基礎(chǔ)

獲得抗體序列��,進(jìn)行多種形式的重組抗體表達(dá)�����,也可實(shí)現(xiàn)抗體人源化

為申請(qǐng)保護(hù)性專利提供有權(quán)單抗序列信息
抗體測(cè)序 * 輝駿優(yōu)勢(shì)

| 
| 
| 
| 
|
保證100%測(cè)序準(zhǔn)確度���, 對(duì)輕鏈的測(cè)序誤差范圍在+/-1.2Da,對(duì)重鏈的誤差范圍在+/-1.8Da | 保證VJC����、DVJC區(qū)域100%覆蓋 | 保證交付抗體活性 | 僅需100μg純化抗體 | 不成功不收費(fèi) |
抗體測(cè)序 * 實(shí)驗(yàn)流程
抗體測(cè)序 * 服務(wù)流程
客戶進(jìn)行抗體驗(yàn)證,我公司根據(jù)反饋結(jié)果重復(fù)實(shí)驗(yàn)或出具測(cè)序報(bào)告(抗體氨基酸序列)

樣本量
100μg單克隆抗體蛋白

濃度
>0.5mg/ml

純度
目標(biāo)抗體占總蛋白量的80%以上

其它
無(wú)相同抗原的抗體蛋白
抗體測(cè)序 * 客戶案例

輝駿實(shí)力
廣州輝駿生物科技股份有限公司成立于2011年�,位于廣州市科學(xué)城,是一家由在生物醫(yī)藥領(lǐng)域具有資深科研資歷人才組建的創(chuàng)新型科技企業(yè)��,致力于為生物醫(yī)藥行業(yè)���、體外診斷行業(yè)���、高?���?蒲袡C(jī)構(gòu)提供高品質(zhì)的技術(shù)服務(wù)�����。
通過(guò)十來(lái)年的發(fā)展�,輝駿生物已經(jīng)建成了完善的抗體蛋白測(cè)序平臺(tái)、重組抗體表達(dá)平臺(tái)��、蛋白質(zhì)組學(xué)技術(shù)平臺(tái)���、分子細(xì)胞生物學(xué)實(shí)驗(yàn)平臺(tái)���。我們專注于品質(zhì)和創(chuàng)新,以極具競(jìng)爭(zhēng)力的價(jià)格和最全面的服務(wù)��,滿足您的實(shí)驗(yàn)需求��,目前已經(jīng)與國(guó)內(nèi)外多家知名企業(yè)建立了合作關(guān)系��。













 實(shí)驗(yàn)熱線:4006991663
實(shí)驗(yàn)熱線:4006991663